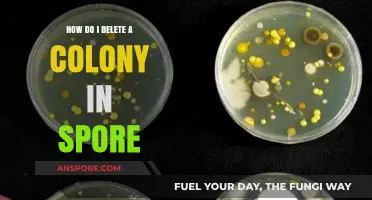
How to Delete a Colony in Spore: Step-by-Step Guide

Applying milky spore is an effective method for controlling Japanese beetle grubs in your lawn. Milky spore, a naturally occurring bacteria called *Paenibacillus popilliae*, targets the larvae of Japanese beetles without harming beneficial insects, pets, or humans. To apply it, start by watering your lawn thoroughly a day before application to ensure the soil is moist. Then, measure and mix the milky spore powder with water according to the manufacturer’s instructions. Using a spreader or sprayer, evenly distribute the solution across your lawn, focusing on areas where grubs are most active. Apply during the late summer or early fall when grubs are actively feeding, and repeat the process annually for several years to establish a robust population of the bacteria. This long-term approach helps reduce Japanese beetle populations and promotes a healthier lawn.
| Characteristics | Values |
|---|---|
| Application Method | Granular application, spread evenly over lawn or affected area |
| Application Rate | 1-2 pounds per 1,000 square feet, depending on severity of grub infestation |
| Application Timing | Apply when grubs are actively feeding (late summer to early fall) and soil temperature is between 60-70°F (15-21°C) |
| Watering After Application | Water lightly (up to 1/4 inch) immediately after application to activate spores |
| Frequency of Application | One-time application, as milky spore multiplies in the soil over time |
| Effectiveness Period | Up to 20 years, as milky spore persists in the soil |
| Target Pests | Japanese beetle grubs, other scarab beetle grubs (e.g., European chafer, May/June beetles) |
| Non-Target Effects | Safe for humans, pets, beneficial insects, and the environment |
| Storage | Store in a cool, dry place; product remains viable for up to 2 years if stored properly |
| Product Form | Granules containing spores of Bacillus popilliae (milky spore disease) |
| Best Time of Day to Apply | Early morning or late afternoon to avoid heat stress on the spores |
| Soil Moisture Requirement | Moist soil is essential for spore germination and infection of grubs |
| Compatibility with Other Products | Can be used alongside other organic lawn care products, but avoid chemical pesticides that may harm milky spore |
| Visible Results | Reduction in grub population and lawn damage may take 2-3 years as milky spore establishes in the soil |
| Application Tools | Spreader (drop or broadcast) for even distribution |
| Precautions | Wear gloves and avoid inhaling dust during application |
Explore related products
What You'll Learn
- Prepare the Area: Mow lawn, water lightly, ensure soil is moist for spore application
- Measure Correctly: Use 1 teaspoon per 4 square feet for even coverage
- Apply Spores: Sprinkle spores evenly, walk in crisscross pattern for thorough distribution
- Water After Application: Lightly water treated area to activate spores in the soil
- Repeat Annually: Reapply every 2-3 years to maintain grub control effectiveness

Prepare the Area: Mow lawn, water lightly, ensure soil is moist for spore application
Before applying milky spore to combat Japanese beetle grubs, proper area preparation is crucial for maximizing its effectiveness. Start by mowing your lawn to a standard height, typically around 2.5 to 3 inches. This ensures that the spore granules can easily reach the soil surface without being obstructed by tall grass. Mowing also helps to create a uniform surface, allowing for even distribution of the product. Think of it as setting the stage for the spore to work its magic—a clean, trimmed lawn is the first step in this biological warfare against grubs.
Once the lawn is mowed, the next critical step is to lightly water the area. The goal here is to moisten the soil to a depth of about 2–3 inches, creating an environment where the milky spore can thrive. Avoid overwatering, as soggy soil can dilute the spores and reduce their potency. A light, even watering with a sprinkler or hose is ideal. Imagine you’re giving the soil a refreshing drink—enough to quench its thirst but not so much that it’s drowning. This moisture helps the spores adhere to the soil particles and begin their journey into the root zone where grubs reside.
Ensuring the soil is moist is more than just a preparatory step; it’s a strategic move to activate the milky spore’s potential. Milky spore (Paenibacillus popilliae) is a bacterium that infects and kills Japanese beetle grubs, but it requires moisture to germinate and spread. Dry soil acts as a barrier, hindering its ability to penetrate the ground and reach its target. By maintaining optimal moisture levels, you’re creating the perfect conditions for the spores to multiply and establish themselves in the soil. This step is particularly important in drier climates or during periods of low rainfall, where the soil might naturally lack the moisture needed for spore activation.
Practical tips can further enhance your preparation efforts. For instance, apply milky spore in the early morning or late afternoon when temperatures are cooler and evaporation rates are lower. This ensures that the moisture you’ve added remains in the soil longer, giving the spores ample time to settle. Additionally, if your lawn has compacted soil, consider aerating it before application. Aeration improves soil structure, allowing water and spores to penetrate more deeply. Think of it as giving the spores a clear pathway to their destination, increasing their chances of success in controlling grub populations.
In summary, preparing the area for milky spore application is a precise process that combines mowing, light watering, and moisture management. Each step serves a specific purpose, from removing physical barriers to creating an optimal environment for spore activation. By following these guidelines, you’re not just applying a product—you’re setting the stage for a natural, long-term solution to grub infestations. It’s a proactive approach that pays dividends in the health and resilience of your lawn.
Propagating Spores Under LED Lights: Tips for Successful Growth
You may want to see also

Measure Correctly: Use 1 teaspoon per 4 square feet for even coverage
Applying milky spore powder with precision is crucial for its effectiveness against Japanese beetle grubs. The recommended dosage—1 teaspoon per 4 square feet—ensures even coverage without waste. This ratio is not arbitrary; it’s calibrated to distribute the spores uniformly across your lawn, maximizing their ability to infect and eliminate grubs. Too little, and you risk leaving patches untreated; too much, and you’ll overspend without added benefit. Think of it as a recipe for lawn health: measure carefully to achieve the desired result.
To implement this, start by dividing your lawn into manageable sections. Use a measuring tape to mark off 4-square-foot areas, or visualize it as a 2-foot by 2-foot square. For each of these sections, measure out 1 teaspoon of milky spore powder. A standard kitchen teaspoon works fine, but consider using a dedicated garden spoon to avoid contamination. Apply the powder evenly across the marked area, either by hand or using a spreader designed for granular products. Repeat this process systematically across your entire lawn, ensuring no section is skipped or double-treated.
While the 1 teaspoon per 4 square feet rule is straightforward, real-world application requires adaptability. For irregularly shaped lawns, break down the space into smaller, measurable segments. Sloped areas may cause powder to run off, so apply sparingly and reapply if necessary. If you’re treating a large lawn, pre-mix the powder in a container with sand or soil to make spreading easier and more consistent. Remember, the goal is uniformity—every grub in your lawn should encounter the spores, and this precise measurement is your best tool to achieve that.
One common mistake is assuming more product equals better results. Milky spore is a biological control, not a chemical pesticide, and its efficacy relies on proper distribution, not concentration. Overapplication won’t speed up the process; it’ll only deplete your supply. Conversely, underapplication leaves grubs unchallenged, prolonging the infestation. Stick to the 1 teaspoon per 4 square feet guideline, and trust the process. Over time, as the spores establish themselves in the soil, you’ll see a natural decline in grub populations—proof that precision pays off.
Finally, consider this measurement as part of a long-term strategy. Milky spore isn’t a quick fix; it’s a gradual, sustainable solution. Applying it correctly the first time ensures the spores can multiply and persist in the soil for up to 20 years. Think of the 1 teaspoon per 4 square feet rule as an investment in your lawn’s future. Done right, it’s a small effort with big, lasting returns—a healthier lawn, fewer pests, and peace of mind knowing you’ve measured, and applied, with care.
Exploring the Intersection: How to Watch Religion of Sports
You may want to see also

Apply Spores: Sprinkle spores evenly, walk in crisscross pattern for thorough distribution
Applying milky spore effectively hinges on even distribution, a task achieved through a deliberate crisscross walking pattern. This method ensures the spores, which target Japanese beetle grubs, are spread uniformly across your lawn. Start by measuring the appropriate dosage—typically 1 to 2 teaspoons of milky spore per 10 square feet—and sprinkle it lightly, as if seasoning a dish. The crisscross technique involves walking in overlapping rows, first in one direction and then perpendicular to it, mimicking the grid of a checkerboard. This approach minimizes gaps and overlaps, maximizing the spore’s reach.
The science behind this technique lies in its ability to mimic natural dispersal patterns. Japanese beetle grubs are not uniformly distributed in soil, so a random scattering of spores would leave some areas untreated. The crisscross method systematically covers the entire area, increasing the likelihood that grubs will encounter the spores. For best results, apply when the soil is moist and the grubs are actively feeding, typically in late summer or early fall. Avoid windy days to prevent spores from drifting off-target.
Practical execution requires a bit of planning. Divide your lawn into sections to ensure consistent coverage, especially in larger areas. Use a shaker bottle or a handheld spreader for precise application, and wear gloves to avoid direct contact with the spores. After sprinkling, lightly water the lawn to activate the spores without washing them away. Patience is key; milky spore is a long-term solution, and results may take a season or two to become apparent.
Comparing this method to broadcast spreading reveals its superiority in targeted pest control. While broadcast methods are efficient for large areas, they often result in uneven distribution, leaving pockets of grubs unharmed. The crisscross technique, though more labor-intensive, ensures thorough coverage, making it ideal for residential lawns where precision matters. It’s a trade-off between effort and efficacy, but the payoff is a healthier, grub-free lawn.
Finally, consider this technique as part of a broader lawn care strategy. Milky spore works best when combined with practices like regular aeration, proper watering, and balanced fertilization. By integrating the crisscross application method, you’re not just treating a problem—you’re investing in the long-term health of your lawn. It’s a methodical approach that rewards attention to detail, turning a simple task into a powerful tool for sustainable pest management.
Do Cocci Form Spores? Unraveling the Truth About These Bacteria
You may want to see also
Explore related products

Water After Application: Lightly water treated area to activate spores in the soil
After applying milky spore to your lawn, the next critical step is to lightly water the treated area. This simple action serves as the catalyst that awakens the dormant spores, setting them on a mission to combat Japanese beetle grubs. Think of it as a gentle nudge that transforms the soil into a battleground where beneficial bacteria outmaneuver pests. Without this moisture, the spores remain inactive, rendering your application ineffective.
The process is straightforward but requires precision. Use a garden hose or sprinkler to deliver a light, even watering across the treated area. Aim for approximately 1/4 inch of water, which is roughly equivalent to 15 minutes of steady sprinkling. Overwatering can dilute the spore concentration, while underwatering leaves them dormant. Picture the soil as a sponge—you want it moist but not saturated. This balance ensures the spores disperse evenly, maximizing their reach and impact.
Timing matters just as much as technique. Water immediately after applying milky spore, especially if rain isn’t in the forecast. Spores need moisture to germinate and begin their work, so don’t leave them stranded in dry soil. If you’re treating a large area, work in sections to ensure each part receives immediate watering. For smaller lawns, a single pass with a sprinkler will suffice. Consistency is key—skip this step, and you’ll undermine the entire application.
Consider environmental factors to refine your approach. In hot, dry climates, water slightly more to counteract rapid evaporation. Conversely, in humid regions, a lighter touch prevents oversaturation. If applying during cooler months, ensure the soil temperature is above 60°F, as spores thrive in warmth. Practical tip: Use a rain gauge or empty tuna can to measure water depth accurately. This small effort ensures your milky spore investment pays off in a grub-free lawn.
Finally, think of this watering step as the final handshake in a partnership with nature. Milky spore is a living organism, and moisture is its lifeline. By providing it, you’re not just following instructions—you’re fostering an ecosystem where beneficial bacteria thrive. The result? A healthier lawn, fewer pests, and a reduced reliance on chemical treatments. It’s a simple act with profound implications, turning your soil into a fortress against grubs.
How to Take a Spore Print on a Notecard: Simple Guide
You may want to see also

Repeat Annually: Reapply every 2-3 years to maintain grub control effectiveness
Milky spore, a natural bacterium, is a powerful ally in the battle against lawn-destroying grubs. However, its effectiveness isn't permanent. Think of it like a vaccine – it needs boosters to maintain its protective power. Reapplication every 2-3 years is crucial to ensure a continuous population of milky spore in your soil, ready to ambush and eliminate grubs before they wreak havoc on your lawn.
Skipping this crucial step leaves your lawn vulnerable to future infestations.
The reapplication process is straightforward. Simply follow the initial application instructions, using the same dosage rates. This typically involves evenly distributing the milky spore powder across your lawn, focusing on areas prone to grub damage. Watering thoroughly after application helps activate the spores and encourages their spread throughout the soil.
Consider this a long-term investment in your lawn's health. While the initial application establishes the milky spore population, regular reapplications ensure its longevity, providing ongoing protection against grubs and the unsightly damage they cause.
Don't wait until you see signs of grub damage to reapply. By then, the damage is already done. Mark your calendar for reapplication every 2-3 years, treating it as a preventative measure rather than a reactive solution. This proactive approach will save you time, money, and the frustration of dealing with a grub-infested lawn.
Remember, consistency is key. Regular reapplications of milky spore are the secret to a healthy, grub-free lawn for years to come.
Can Disinfectants Effectively Eliminate Mold Spores? The Truth Revealed
You may want to see also
Frequently asked questions
Milky spore is a natural, granular bacteria-based product (Paenibacillus popilliae) used to control Japanese beetle grubs in lawns. It works by infecting and killing the grubs, which are the larvae of Japanese beetles, disrupting their life cycle and reducing future beetle populations.
The best time to apply milky spore is during late summer or early fall when the grubs are actively feeding in the soil. This timing ensures the bacteria come into contact with the grubs, maximizing effectiveness.
To apply milky spore, evenly distribute the granules across your lawn using a spreader, following the package instructions for the correct application rate. Water the lawn lightly after application to activate the spores and help them penetrate the soil. Repeat the application annually for 2-3 years to establish the bacteria in the soil.